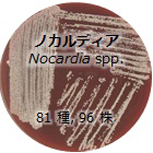
ノカルディア属のモデル写真です

MALDI-TOF MS 微生物同定用ライブラリーに使用した微生物
- 【更新しました】
- MALDI Biotyper®に対応したAlicyclobacillus属細菌種(新属Paenalicyclobacillus属細菌種含む)のMALDI-TOF MS微生物同定用ライブラリーを拡張し、全118ライブラリーの提供を開始しました。(2026.5.13)
ここでは、NITE が提供している MALDI-TOF MS 微生物同定用ライブラリーに使用した微生物について紹介しています。
アリシクロバチルス属

Alicyclobacillus属は、好気性、好酸性のグラム陽性芽胞形成細菌で、高温域でも生育し、食品衛生法で指定されている殺菌法では死滅しないことから、飲料品の事故に繋がるケースがあります。中でも薬品臭をもつグアイアコールを産生して食品の品質低下を引き起こすAlicyclobacillus acidoterrestris等は、食品産業界、特に飲料業界において問題視されています。本属は、2025年に再分類され、一部はPaenalicyclobacillus属として提唱されました※。NITEでは、26種56株(Paenalicyclobacillus属細菌種を含む)についてMALDI-TOF MSで分析し、MALDI BiotyperⓇに対応したライブラリーを作成・提供しています。
※ Damst'e, J.S. et al. (2025). Syst. Appl. Microbiol. 48, 126651及びCandidatus含む
クラドスポリウム属

クラドスポリウム(Cladosporium)属は一般にクロカビと呼ばれ、土壌や住環境などの幅広い環境で見つかります。これらの多くは空中浮遊する胞子を作り、空調機器などを通じて住環境へ放出されることで食品汚染、浴室の壁やカーテンなどの布地の黒色変化の原因となるほか、ぜんそくなどの呼吸器系疾患の原因となる菌としても知られています。
分類体系は非常に複雑で、複数の遺伝子領域から種の判別を行う必要があり、簡便な識別方法が望まれています。
NITEでは、市販ライブラリーに含まれていない4種16株をMALDI-TOF MSで分析し、MALDI BiotyperとSARAMISに対応したライブラリーを作成・提供しています。
乳酸菌類

ラクトコッカス属はヨーグルト等の乳酸発酵食品に多く含まれるグラム陽性菌で、特に Lactococcus lactis は乳酸菌として最初に発見された種です。ラクトコッカス属は以前はストレプトコッカス属に位置づけられており、口腔、人畜、臨床試料などに見い出される乳酸菌とも深い関係があります。
ロイコノストック属は、生成する乳酸の異性体がD型となるヘテロ発酵型の乳酸菌です。なかでも Leuconostoc mesenteroides は植物の発酵に関係が深く、農場のサイレージ、ザワークラウト、ワインの製造過程に存在します。一方、希にヒトに対して日和見感染症を発症させる報告例もあります。
ラクトバチルス属注は、古くからヨーグルトの製造に利用されてきている乳酸菌です。一方、日本酒醸造の現場では、日本酒の風味の劣化の原因である火落ち菌としても有名です。
NITEでは、ラクトコッカス属、ロイコノストック属の18種33株をMALDI-TOF MS で分析し、MALDI Biotyper とSARAMIS に対応したライブラリーを作成・提供しています。ラクトバチルス属は18種57株をMALDI-TOF MSで分析し、MALDI Biotyper とSARAMIS に対応したライブラリーを作成・提供しています。
注:Zheng, J. et al. (2020). Int. J. Syst. Evol. Microbiol. 70, 2782-2858.により異なる属に再分類された種を含む。
サッカロマイセス属

狭義のサッカロマイセス(Saccharomyces sensu stricto)は、アルコール発酵を行うことでパンやワイン、ビールなどを作る菌を含むことで知られています。
食品などに利用できる有用な菌が多く含まれるため、簡便かつ精度の高い識別・同定が望まれる一方、それぞれの菌種同士が非常に近縁で従来法では識別・同定が非常に困難です。
NITEでは、10種99株をMALDI-TOF MSで分析し、MALDI BiotyperとSARAMISに対応したライブラリーを作成・提供しています。
黒麹菌の類縁菌

黒麹菌は胞子の色が黒褐色の糸状菌で、土壌や空気中、パンや穀物で見つかります。これらの仲間であるAspergillus nigerをはじめとする数菌種は、発がん性のあるカビ毒(オクラトキシンほか)を産生し、食品汚染やハウスダストなどの呼吸器系の疾患の原因となる危害菌として知られています。
一方、Aspergillus awamoriをはじめとした酒類の醸造や酵素の製造に用いられる有用な菌種も黒麹菌の仲間に含まれています。
NITEでは、黒麹菌のうち14種49株をMALDI-TOF MSで分析し、MALDI BiotyperとSARAMISに対応したライブラリーを作成・提供しています。
アシネトバクター属

アシネトバクター属は、土壌や河川水などの自然環境中に広く生息するグラム陰性細菌で、約60種が存在します。環境汚染物質分解菌や原油分解菌などの産業上有用な株が存在する一方、A. baumannii、A. haemolyticus をはじめとする病原菌種が存在し、更にいくつかのアシネトバクター属種は多剤耐性を獲得し、世界的な問題となっています。
NITE では、34 種 71 株を MALDI-TOF MS で分析し、MALDI Biotyper と SARAMIS に対応したライブラリーを作成・提供しています。
シュードモナス・プチダ類縁菌

シュードモナス(Pseudomonas)属は土壌などあらゆる環境に広く分布する細菌で、多様な分解能力に富むグラム陰性の桿菌です。特に Pseudomonas putida は、その優れた油分解能力により環境浄化(バイオレメディエーション)に利用可能として世界で初めて特許登録された種です。P. putida グループは 16S rRNA 配列だけでは近縁種同士の識別が難しく、簡便で同定精度の高い方法の開発が望まれています。
ノカルディア属
放線菌の仲間で、土壌中に広く存在します。ノカルディア(Nocardia)属は偏性好気性で細胞壁中に抗酸性を有しています。一般に長い菌糸状で、やがてそれが分断して桿状または球状の細胞となります。一方、ヒトや動物に対して、ノカルディア症(日和見感染症)の原因となる種(N. asteroides, N. brasiliensis, N. farcinica, N. nova, N. otitidiscaviarum, N. transvalensis など)が存在します。また、N. vaccinii は植物へ、N. salmonicida は魚類への病原性が報告されています。
NITE では、81 種(invalid name を含む) 96 株を MALDI-TOF MS で分析し、SARAMIS に対応したライブラリーを作成・提供しています。
黄麹菌の類縁菌

Aspergillus 属は世界中に広く分布する糸状菌で、本属の中に 1000 種近くが知られています。その多くは土壌の腐生菌や空中浮遊菌ですが、コウジカビ(A. oryzae、A. sojae)は、酒をはじめとする発酵食品製造に使用されます。一方、食品・製品を腐敗・劣化させたり、マイコトキシンを産生したり(A. flavus, A. parasiticus)、肺疾患を引き起こす種も存在しており、有用菌種と有害菌種が近縁で判別が難しい菌種です。
NITE では、10 種 127 株を MALDI-TOF MS で分析し、MALDI BiotyperとSARAMIS に対応したライブラリーを作成・提供しています。
お問い合わせ
- 独立行政法人製品評価技術基盤機構 バイオテクノロジーセンター バイオ技術評価・開発課(かずさ)
-
TEL:0438-20-5764
住所:〒292-0818 千葉県木更津市かずさ鎌足2-5-8 地図
お問い合わせフォームへ








